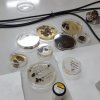
tartufi di varie specie

Nei giorni 8, 9, 10, 15 e 16 marzo 2016, presso l'Università di Basilicata, si è svolto il "I° Corso di Microscopia Ottica" organizzato dall' Associazione Sostenitori Cultura Idnologica Lucana (ASCIL).
I docenti del Corso sono stati il Prof. Renato Spicciarelli, entomologo e Responsbile Scientifico del Museo di Storia Naturale del Vulture ed il Prof. Gian LUigi Rana, fitopatologo vegetale e Presidente dell'ASCIL.
I partecipanti si sono ritrovati nella Biblioteca dell'A.S.C.A.F. per una prima fase teorica. Successivamente si sono trasferiti nel Laboratorio di Microscopia Ottica della Scuola di Scienze Agrarie, Forestali, Alimentari ed Ambientali (S.A.F.E.) dello stesso Ateneo per svolgere un'interessantissima fase pratica.
Entusiasmo dei partecipanti per l'esposizione chiara e comprensibile del Prof.Spicciarelli e per l'eccellente organizzazione curata dal Prof. Rana e dai suoi collaboratori.
Un particolare ringraziamento al Direttore della S.A.F.E., Prof. Severino Romano, ed al responsabile della Biblioteca dell'A.S.C.A.F., Prof. Domenico Pierangeli, per la grande disponibilità e la cortese ospitalità.
Il Corso ha avuto il seguente svolgimento.
Dr. Antonio Pagano (Vice Presidente ASCIL)
N.B. Se vuoi consultare il corso completo, diventa socio ASCIL e consulta il menu "Gli esperti", sottomenu "Entomologia", voce "Renato Spicciarelli".